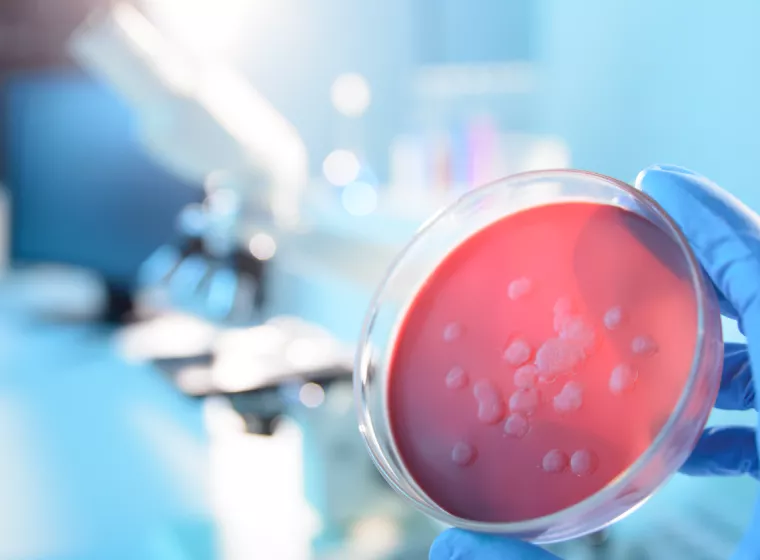
Red specimen in science petri dish. Exponent conducts rigorous epidemiological research to evaluate emerging diseases.

Our Work in the Life Sciences & Healthcare Industries

Pharmaceuticals
Providing science-based strategy and innovative research solutions across the full scope of clinical development, from preclinical studies to post-marketing surveillance; generating real-world evidence (RWE) for small-molecule, cell, and gene therapies; and prescription digital therapeutics.

Medical Devices
Evaluating catheters, stents, artificial discs, joint replacements; analyzing cutting-edge electronic and radio-frequency devices, innovative software-as-a-medical device products, and more.

Combination Products
Assisting with design review, evaluation, and regulatory strategy for products spanning tried and true injectables, leading-edge devices, and digital health innovations.

Supporting the full range of in vitro and companion diagnostics, including high-throughput clinical laboratories, point-of-care, and at-home testing products.

Over-the-Counter Drugs
Researching safety and efficacy evidence, identifying interactions, aiding regulatory approval, and supporting manufacturing quality.
Partnership for the Long Term
We support our life sciences clients across the total product lifecycle, helping you bring therapeutics to market and improve human health by solving critical design, regulatory, safety, and market access challenges. We can collaborate with you throughout your journey, helping you navigate risks and opportunities — and optimize outcomes — with science-based strategies and specialized expertise. Download our services brochure here.
We help our clients with:
What Can We Help You Solve?
Across decades of work with life sciences and healthcare products, we've developed specialized capabilities to address the most vital challenges. And we thrive on innovating new ways to help.

Healthcare and Life Sciences Value & Outcomes Assessment
Strategic guidance for medical product value and access, including drugs, vaccines, and medical devices.

Medical Device Design & Development Support
Crucial medical device design and development analyses to empower your decision-making.

Clinical & Pharmacoepidemiology
Rigorous pharmacoepidemiology studies and clinical trials.

Life Sciences Due Diligence
Due diligence technical consulting services to help verify the science and technology behind medical devices and related therapeutics.
Emerging Infectious Diseases
Scientific research, strategy, and tactics to support strategic planning related to numerous aspects of emerging infectious diseases.

Biomedical Engineering Laboratories
Expert biomedical laboratory services, delivering evidence-based answers for your most complex challenges.

Health Risk Assessments
Identify risks, hazards, and liabilities to improve occupational health and safety.
.png3951.webp?itok=ScUFitF1)
Medical Device Evaluation
Sophisticated medical device evaluations for a vast array of applications.
![User Research & Testing [HF]](webp/gettyimages-1338374024.jpg935a.webp?itok=bBXBoCIg)
Medical Device Usability Testing
Extensive human factors evaluations for medical device manufacturers in developing and navigating regulatory roadmaps.

Materials Used in Medical Devices, Implants & Surgical Tools
Expert evaluation of the materials used in medical devices, implants, and surgical tools.

Medical Technology Assessment Program
Rapid, expert assessments of medical devices and technologies, surgical implants, and wearable medical technologies.

Multidisciplinary Expertise to Support the Life Sciences Industry
Support for next-gen medical devices, wearable technologies, and pharmaceutical products.

Multidisciplinary Expertise for Pharmaceutical Testing & Modeling
Evaluate pharmaceuticals with pharmacodynamic modeling, clinical epidemiology, and pharmacoepidemiology studies.

Occupational & Environmental Epidemiology
Advanced epidemiological research and evidence-based insights from leading epidemiologists and biostatisticians.

Drug Safety & Risk Management
Determine the optimal strategies, methods, and solutions to align with specific products, patients, populations, and situations.

Regulatory Compliance for Medical Products
Experienced regulatory support for medical devices, pharmaceuticals, and combination products.

Biomedical Expertise for Therapeutic Areas
Multidisciplinary insights for a range of therapeutic product development challenges.

Drug Safety & Risk Management
Determine the optimal strategies, methods, and solutions to align with specific products, patients, populations, and situations.













